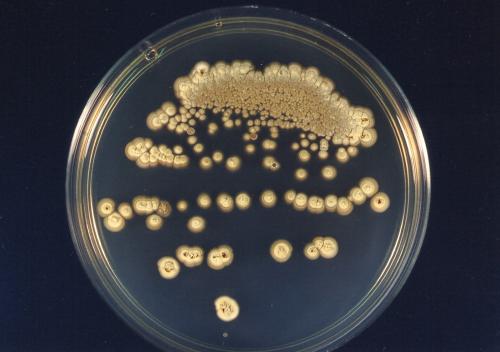
10 интересных фактов о бананах » Вестник К. 10 фактов про бананы 01

10 интересных фактов о бананах » Вестник К. 10 фактов про бананы
- 10 интересных фактов о бананах » Вестник К. 10 фактов про бананы
- 13 смешных фактов о здоровом питании
- Интересные факты о еде в разных странах
- Интересные факты о дрожжах раскрывает эксперт Брянской испытательной лаборатории ФГБУ «ВНИИЗЖ»
- Интересные факты о полезной еде. Интересные факты о правильном питании
- Интересные факты о еде в россии. Салаты
- Интересные факты о помидорах. Интересные и малоизвестные факты о помидорах
- Интересные факты о кухне. Интересные факты о кухнях разных народов мира
- Интересные факты об апельсиновом соке. Полезные свойства
10 интересных фактов о бананах » Вестник К. 10 фактов про бананы
Бананы-мои самые любимые ягоды и я хочу поделиться фактами, которые знаю про них.
Факты:
1 факт
Бананы содержат в общей сложности 89 калорий на 100 граммов .
2 факт
Банан – четвертый по популярности сельскохозяйственный продукт, выращиваемый в мире.
3 факт
Здоровый фрукт для завтрака, банан, назван так потому, что происходит от слова «банан», которое в переводе с арабского означает «палец». Один банан, несколько напоминающий форму человеческого пальца, называется пальцем и присоединяется к группе других бананов, называемой «рукой».
4 факт
На каждом стебле получается от 9 до 12 рук (рядов бананов). И каждая рука вырастает от 14 до 20 пальцев (или отдельных бананов).
5 факт
Все бананы без косточек, которые мы едим сегодня, получены из двух диких видов: Musa acuminata и Musa balbisiana. Однако разновидностей бананов может быть более 1000.
Взято из общего доступа.
6 факт
Бананы, которые вы найдете в супермаркетах и на фермерских рынках, выращиваются в коммерческих целях, поэтому семена внутри превратились в черные незрелые пятнышки.
7 факт
Бананы могут помочь снизить кровяное давление и защитить сердце из-за высокого содержания калия и низкого содержания соли.
8 факт
Бананы можно считать усилителем настроения, потому что они содержат аминокислоту, триптофан и витамин B6, которые помогают организму вырабатывать серотонин.
9 факт
Внутренняя часть кожуры банана может помочь уменьшить зуд и воспаление, например от укусов насекомых или ядовитого плюща.
10 факт
«Банановая республика» – это термин, используемый в политической науке, который описывает политическую нестабильность в латиноамериканской стране, которая экономически зависит от экспорта продуктов с ограниченными ресурсами, таких как минералы, бананы.
13 смешных фактов о здоровом питании
иногда лазая по различным сайтам, находишь много чего интересного. вот например вот это)))
1. Яйцо , сваренное вкрутую, можно раскрутить вокруг собственной оси. Сырое или сваренное всмятку яйцо вращаться не будет. Отличный способ проверить, насколько безопасны ваши запасы для путешествия.
2. Миндаль – близкий родственник сливы и вишни. Все они относятся к подсемейству сливовых. Только у миндаля косточка съедобная.
3. Яблоня – родственница розы . Теперь у вас есть законное основание дарить пакет яблок вместо традиционного букета. Впрочем, подарить вместе с яблоками груши, миндаль, вишню с черешней или ту же сливу – тоже уместно. Все это ботаническое семейство «Розовые».
4. Бананы – не фрукты. Банановое дерево – это трава . К сожалению, бананы нельзя отнести ни к зерновым, ни к салатной зелени. А жаль, они так хорошо повышают настроение!
5. А вот кофе – это ягоды. Точнее, семена ягод кофейного дерева.
6. Наиболее географически распространенное во всем мире молоко – козье . Поскольку козы могут жить и кормиться там, куда ни одна корова не забредет.
7. Морковь сначала выращивали не ради сладкого корня, а для получения ароматных зерен и зелени, которые использовались как специи и лекарства. В Европе этот корнеплод считается овощем и фруктом одновременно . Португальцы, например, производят и продают морковный джем.
Главное на портале:
8. Родиной кетчупа считают Америку, но продукт питания, который носил такое название, в XVII веке привезли из Китая в Англию. Тогда в его состав входили анчоусы, орехи и грибы, а томатов не было и в помине. Видимо, красителей и консервантов тоже – вплоть до появления в начале XX века бензоната натрия.
9. Рисом питается половина населения земного шара . В России он известен со Средневековья под названием «сарацинское пшено», но массово выращивать рис начали только в XIX веке. Зато в исламских странах существует мера веса, равная одному рисовому зерну – арузза, составляющая 0,0186 г. Полчаса золушкиного труда – и вы точно подсчитаете, сколько весит рис для вашей утренней каши .
10. В клубнике больше витамина С, чем в апельсине . А в петрушке или сладком перце – еще больше. В то же время всего полпачки сигарет в день сводят на нет результаты поедания двух грейпфрутов.
11. Ошибка в тексте , превратившая шпинат в мощнейший источник железа , породила масштабную рекламную компанию и создала Моряка Попая. Благодаря этому персонажу в 1931 году американцы съели на 30 процентов больше шпината, чем в предыдущие годы. На самом деле железо в шпинате есть, но его гораздо меньше, чем ошибочно предполагалось. Основные причины любить шпинат – наличие в нем фолиевой кислоты и биофлавоноидов .
12. Помидоры долгое время считались ядовитыми . Репутацию этим ягодам подпортила близкая родственница из семейства пасленовых – картошка . Ягоды картошки действительно ядовиты и похожи на помидоры, только маленькие.
13. В XVI веке случилась богословская дискуссия на тему, считать ли потребление шоколада грехом чревоугодия . Тогда обошлось – сослались, что для грешной пищи шоколад слишком горек. Впрочем, некоторые считают употребление шоколада грехом и сейчас, только диетическим: стандартная плитка молочного шоколада по калорийности может составить половину дневного рациона.
Тем не менее, в шоколаде содержится вещество фенилэтиламин, который участвует в производстве гормонов удовольствия . Он выделяется в головном мозге после курения марихуаны и употребления алкоголя, а также во время влюбленности. Мораль проста: влюбляться и есть шоколад – безопасная разновидность достижения эйфории.
Интересные факты о еде в разных странах

1. Так как жители Японии с древних времен ели много морепродуктов, в их пищеварительной системе появились особые микроорганизмы, позволяющие эффективнее расщеплять такую пищу.
2. Первоначально европейцы употребляли в пищу ботву, а не плод моркови. В Португалии до сих пор готовят джемы из морковной ботвы.
3. В странах Скандинавии есть несколько традиционных блюд из испорченной рыбы – в Исландии готовят хакарл из протухшего акульего мяса, а в Швеции большой популярностью пользуется сюрстремминг из прокисшей селедки.
4. В Чили не принято есть руками – что бы ни лежало на тарелке, воспитанный человек должен использовать столовые приборы.
5. Популярную в Китае лапшу нельзя разрезать на кусочки, так как она символизирует долголетие и здоровье.
6. В Японии принято громко чавкать во время еды, особенно при поедании супов и лапши. Так японцы демонстрируют повару, насколько им понравилось угощение.
7. В Казахстане гостям никогда не наливают полную чашку чая, так как ухаживание за ними считается приятной и почетной обязанностью. Если же казах все же наполнил чашку до краев, значит, посетителю в доме не рады.
8. Во Франции хлеб принято класть на стол, а не на край тарелки. Кроме того, поедание булочек или тостов до основного блюда считается дурным тоном.
9. Глава католической церкви объявил крупного южноамериканского грызуна капибару рыбой, чтобы мясо этих зверьков можно было есть в пост. Блюда из этих родственников морских свинок до сих пор присутствуют в кухне многих стран мира.
10. Самое большое блюдо в мире – жареный верблюд, которого издревле готовят в Марокко. Тушу животного фаршируют целым бараном, 20 курицами, 60 яйцами и другими ингредиентами.
11. Французский сыр камамбер становится особенно вкусным перед истечением срока его годности.
12. В Китае и Японии чрезвычайно популярны десерты из лепестков хризантемы.
13. Украшать блюда веточкой петрушки первыми начали древние римляне – они верили, что это растение способно нейтрализовать яд, если пища была отравлена врагами.
14. Ежедневно около 27 миллионов американцев едят в заведениях сети McDonald’s.
15. На Филиппинах кокосовый орех, расколотый без зазубрин, считается хорошей приметой.
16. До середины 19 века во французских ресторанах гостю приносили все заказанные блюда разом. Затем Париж посетил русский князь и рассказал об альтернативной подаче, когда еду приносят постепенно, в том порядке, который значится в меню. Этот способ подачи начали использовать повсеместно и до сих пор называют его service a la russe.
17. Законодатели Евросоюза официально признали фруктами огурцы, помидоры, тыкву, ревень, морковь и имбирь.
18. В Японии хорошим тоном считается есть суши руками – так гость ресторана демонстрирует уважение к повару.
19. Пирожное «Наполеон» было впервые приготовлено московскими кондитерами в честь столетия изгнания французского императора из России. Первоначально десерт был треугольным в напоминание о головном уборе француза.
20. В Древней Руси борщом называли отвар борщевика на свекольном квасе.
Интересные факты о дрожжах раскрывает эксперт Брянской испытательной лаборатории ФГБУ «ВНИИЗЖ»
Открытие дрожжей значительно продвинуло вперёд не только промышленность, но и медицину. Сейчас они применяются в самых разных областях, служат для приготовления разнообразных напитков и блюд, используются как биологически активные добавки в медицине и процессе производства этанола, экологически чистого биотоплива. Что же такое дрожжи, чем они полезны или вредны? Разобраться в этом нам поможет ведущий микробиолог отдела пищевой микробиологии и ветеринарно-санитарной экспертизы Брянской испытательной лаборатории ФГБУ «ВНИИЗЖ» Елена Ковалева.
Открытие дрожжей значительно продвинуло вперёд не только промышленность, но и медицину. Сейчас они применяются в самых разных областях, служат для приготовления разнообразных напитков и блюд, используются как биологически активные добавки в медицине и процессе производства этанола, экологически чистого биотоплива. Что же такое дрожжи, чем они полезны или вредны? Разобраться в этом нам поможет ведущий микробиолог отдела пищевой микробиологии и ветеринарно-санитарной экспертизы Брянской испытательной лаборатории ФГБУ «ВНИИЗЖ» Елена Ковалева.
Что такое дрожжи?
Дрожжи являются одноклеточными неподвижными микроорганизмами небольшого размера (10-15 мкм), относятся к микроскопическим грибам царства Mycota. Они встречаются в почве, на листьях, плодах и стеблях растений, в пищевых субстратах растительного и животного происхождения. На сегодняшний день их насчитывается около 1500 различных видов.
Когда впервые они были обнаружены?
В 1680 году натуралист Антони Ван Левенгук смог рассмотреть дрожжи при помощи микроскопа и с поразительной точностью передал изображение дрожжевой клетки в своих рисунках. Участие дрожжей в биологическом процессе спиртового брожения научно доказано и официально зафиксировано только лишь в 1857 году благодаря трудам великого микробиолога Луи Пастера.
Как среда обитания влияет на жизнедеятельность дрожжей?
Условия обитания влияют не только на способ размножения дрожжей, но и на их жизнедеятельность в целом. Оптимальные условия для нормального функционирования дрожжевых грибов следующие: жидкая среда (желательно кислая, то есть с pHВредны ли дрожжи?
Единого мнения по этому вопросу нет. Все виды дрожжей не являются опасными микроорганизмами, но и полностью безвредными их нельзя назвать. Польза дрожжей заключается в том, что они богаты важнейшими питательными веществами, витаминами группы В (кроме В12), аминокислотами, фосфором. 5-7 граммов пивных дрожжей в организме человека покрывают недостаток витамина В. Но дрожжи приносят человечеству не только пользу. Некоторые виды дрожжей могут стать причиной серьёзных желудочно-кишечных заболеваний как у людей, так и у животных. Польза и вред того или иного вида дрожжевых грибков зависят от ситуации, состояния здоровья живого организма и многих внешних факторов. В небольших количествах микроорганизмы положительно влияют на здоровье, но их избыток может принести вред.
В рамках микробиологического контроля продовольственного сырья специалисты отдела пищевой микробиологии и ветеринарно-санитарной экспертизы Брянской испытательной лаборатории ФГБУ «ВНИИЗЖ» проводят лабораторные исследования по определению количества дрожжей в пищевых продуктах.
Получить подробную информацию о порядке проведения и стоимости исследований можно по адресу: Брянская область, Брянский район, с. Супонево, ул. Шоссейная 7. Тел. 8 (4832) 92-17-40, почта: bmvl32@fsvps.gov.ru , VK: arriah_bryansk и Telegram: t.me/bmvl32.
Интересные факты о полезной еде. Интересные факты о правильном питании
О правильном питании сказано уже немало и его принципы многие выучили наизусть, поэтому иногда повторение одного и того же начинает утомлять. Но даже в такой избитой теме можно найти такую информацию, которую знает далеко не каждый. Итак, интересные факты о правильном питании.
Мы думаем о еде около ста раз в день
Да-да, в течении дня нам приходится около 100 раз принимать пищевые решения. Тут есть маленькая подсказка от одного диетолога: если девяносто раз была выбрана полезная еда, то в оставшиеся десять можно и позволить себе кулинарные вольности. Действительно, для того, чтобы быть в форме и сохранять здоровье вовсе не нужно становиться аскетом и питаться только безупречно правильно. Поэтому раз в неделю можно без вреда позволить себе и кусочек торта (не весь торт), и одно пирожное, и тарелку пельмешек. Исключение могут составить разве что спортсмены на этапе сушки – там все строго, сколько ни думай.
В молоке с пониженным содержанием жира больше кальция
Оказывается, жир вытесняет кальций, поэтому вытесняя жир из молока (но не полностью, немного жира оставим), на производстве повышают количество кальция в каждой чашке. Кстати, кости организма полностью обновляются за семь лет, так что еще есть возможность укрепить скелет у каждого. Кроме того, приятным бонусом в таком молоке будет снижение количества насыщенных жиров – их есть надо, но совсем чуть-чуть.
Раздельное питание с недоказанной эффективностью
Именно так: эффективность раздельного питания научно не доказана. Все остальные заявления голословны и не имеют достаточной исследовательской базы (пары коллег и просто самих по себе похудевших знакомых маловато). Вот порядок приема – это другой вопрос. Поскольку растительная пища (овощи и фрукты) перевариваются преимущественно в кишечнике, то их лучше «пропускать вперед», а только потом есть крупы и мясо. Тогда получится избежать брожения и вздутия живота.

Здоровое питание можно заказать на дом
Это действительно так. И впрямь можно сделать так, чтобы вам привозили в коробочках не лапшу и картофель фри, а прекрасные здоровые завтраки обеды и ужины, плюс перекусик, если предусмотрен. Для этого достаточно обратиться в компанию Grow Food – и правильное питание с доставкой на дом будет вашим спасением от кулинарных марафонов. Все блюда составлялись лучшими фитнес-тренерами Санкт-Петербурга и готовились командой высокопрофессиональных поваров. Таким образом, вместо вредных жирных и калорийных блюд к вам домой приедет сбалансированное меню, которое подарит ощущение сытости и довольства собой.
Есть после шести можно
И даже нужно, если вы ложитесь после 10 вечера. Достаточно кушать последний раз за три-четыре часа до сна – этого вполне достаточно, чтоб еда переварилась и не мешала организму спокойно отдыхать. Кроме того, если очень хочется есть, а на часах уже девять вечера – спокойно выпейте стакан не очень жирного кефира и не мучайте себя. От такого перекуса калорий лишних не прибавится и желудок не будет перегружен.
Меню правильного питания может состоять из неповторяющихся блюд
Причем тут даже не идет речь о том, что куриная грудка с солью и куриная грудка с петрушкой – это разные блюда. Здесь говорится о компании Grow Food , которая готова предоставить своим клиентам семидневное меню без повторяющихся блюд, причем все они ресторанного уровня и сбалансированного состава. Если вы считаете, что это действительно интересные факты о правильном питании, то просто зайдите на сайт компании и проверьте все их в действии – они реально работают.
Интересные факты о еде в россии. Салаты
Русские салаты – отнюдь не тот раздел меню, где фигурируют древние блюда. Более того, блюдо под названием «русский салат» легче встретить в ресторанах Западной Европы, а в России оно известно под другим названием – «оливье».
Но некоторые овощные закуски все же можно счесть национальной едой России.
Винегрет – салат из отварной свеклы, картофеля и моркови с зеленым горошком и солеными огурцами. Огурцы иногда заменяют квашеной капустой или солеными грибами, а горошек – фасолью. Заправляют винегрет растительным маслом.

Селедка под шубой – закусочное блюдо, для приготовления которого послойно выкладывают натертый отварной картофель, нарезанное кусочками филе сельди, лук, тертую вареную морковь, свеклу и мелко нарезанные яйца. Слои перемазывают майонезом.
Соленья – незаменимый источник витаминов в холодное время года. Чтобы сохранить продукты до весны, на Руси квасили капусту, солили огурцы и грибы, делали моченые яблоки, клюкву и бруснику.
Супы
Когда-то суп в России был основным блюдом. Сейчас основным он быть перестал, но важным – остался.
- Щи – широко известное национальное блюдо России, суп из свежей или квашеной капусты на говяжьем бульоне. В пост готовят грибные щи. Для придания характерного кислого вкуса в суп добавляют капустный рассол, яблоки, щавель.

- Похлёбка – легкий овощной суп с одним основным ингредиентом. Например, в картофельную похлебку для вкуса добавляли только жареный лук, чечевичную похлебку сдабривали луком и морковью.
- Солянка – наваристый и пряный суп из нескольких сортов мяса и субпродуктов. В солянку также обязательно кладут соленые огурцы, часто добавляют лимон и оливки. Помимо мясной, солянка бывает рыбная и грибная.
- Рассольник – мясной или рыбный суп с овощами, крупой и солеными огурцами. Кисловатый вкус усиливают добавлением сметаны.
- Уха – суп, как правило, из речной рыбы. Кроме обычной ухи, существует еще двойная и тройная: в этом случае сначала варится бульон из малоценной мелкой рыбы, а потом в суп закладываются куски судака, сига, а то и стерляди. Прозрачный, наваристый бульон – самое главное в ухе, а потому овощей в нее кладут по минимуму (только картошку, морковь и лук) и нарезают их крупными кусками, а то и вовсе закладывают целиком. В поморскую уху добавляют молоко.

Летом в России готовят холодные супы – окрошку, свекольник, ботвинью. Их основу составляют свежие овощи – редиска, свежие огурцы, отварной картофель и морковь, отварное мясо и зелень.
Основа заливается холодным несладким квасом, сывороткой, разведенным кефиром или свекольным отваром.
Мясные блюда
В перечне традиционных блюд России не так много мясных кушаний. Мясо вплоть до XVII века было редкостью на столах, его готовили в основном на праздники.
Тогда вариантов было несколько: мясо отваривали или запекали большим куском, субпродукты пекли вместе с кашами в горшках, а птицу, в том числе дичь, жарили. Большинство рецептов мясных блюд довольно поздние, и народными их не назовешь.
Жаркое – крупный кусок говядины, зажаренный с кореньями, а затем доведенный до готовности в духовке. Готовое жаркое поливали особым овощным или ягодным соусом. Жаркое также делают из дичи: оленины, медвежатины, зайчатины.
Пельмени – небольшие конвертики из теста с мясной, реже с овощной начинкой. Изначально это было блюдо уральских народов, но теперь его готовят повсеместно.
Пельмени чаще всего варят и подают со сливочным маслом, со сметаной, хреном или уксусом. Иногда отваренные пельмени поджаривают. Мелкие пельмешки используют как заправку для бульона.
Буженина – запеченная свиная или говяжья вырезка (оковалок, окорок). Иногда мясо сначала маринуют, отваривают, а затем запекают.
Холодец, или студень – отварное мясо в крепком застывшем бульоне. Холодец готовят из говядины, свинины, птицы, мясо перед заливкой бульоном приправляют чесноком.
Пожарские котлеты – котлеты из мяса птицы в сухарной панировке.
Мясо по-строгановски, или бефстроганов – мелко нарезанная говядина, обжаренная и залитая сметанным соусом.

Интересные факты о помидорах. Интересные и малоизвестные факты о помидорах
Самый большой в мире томат вырастил американец Дэн Маккой. Вес овоща - 3 кг 810 г - зафиксирован в Книге рекордов Гиннесса.
Сок от пота
Китайские ученые сообщили, что свежевыжатый томатный сок отлично помогает бороться с повышенной потливостью и неприятным запахом в жаркое время года. Мол, он, как и семена нима (их можно купить в специализированных магазинах благовоний и прочих субстанций для улучшения психологического состояния), наделен антисептическими свойствами, поэтому помогает уничтожать микроорганизмы. Ко всему прочему, томатный сок снижает температуру тела. Нужный эффект достигается как при приеме внутрь, так и в виде омовений.
Рецепты для звезды
Актер Андрей Мерзликин сфотографировался в помидорных зарослях и бросил в «Инстаграме*» клич:
«Две недели они нас кормят, а теперь уже такой урожай, что «ломаем голову», что с ними делать… Есть рецепты?»
Подписчики тут же закидали актера рецептами. Например, можно запечь половинки в духовке с черным перцем и чесноком. Подавать с крупной солью и соевым соусом. Посоветовалипосолить по-монастырски. В бочку или бак слоями укладываете зелень, чеснок и помидоры вверх цветоножкой, заполненной солью. Емкость накрываете полотенцем и оставляете на 2 - 3 дня до появления лужицы в соли. Потом заливаете холодным рассолом (1 ст. ложка соли на литр) и придавливаете гнетом на 50 дней. Вкус фантастический: надкусываем шкурку и высасываем вкусноту.

Изображение:instagram.com
Как ягода стала овощем
- V век до н. э. Согласно исследованиям ботаников и находкам археологов, разводить помидоры начали перуанцы. Тогда они были маленькие (как нынешние черри) и вишневидной формы.
- 1493 г. Колумб привез томаты в Испанию среди прочих диковинок своей первой экспедиции в Южную Америку. Из-за резкого запаха и яркого цвета люди боялись их есть, считая ядовитыми.
- 1776 г. Во время борьбы американских штатов за независимость повар Джорджа Вашингтона попытался отравить его мясом, сваренным с помидорами. Президент США остался доволен кушаньем, а повар в страхе перед расплатой перерезал себе горло. С тех пор томаты перестали считать ядовитыми.

- 1780 г. Русский посол в Италии презентовал Екатерине II корзинку помидоров. Плоды так понравились императрице, что она приказала регулярно доставлять их к ее столу. Так в столицах узнали о томатах, которые уже лет 30 с успехом выращивали на окраинах: в Крыму, Астрахани, Тавриде, Грузии.
- 1801 г. В кулинарных книгах появился рецепт кетчупа Сэнди Эдисона , в состав которого, кроме анчоусов, лука-шалота, уксуса, белого вина, пряностей, лимонной цедры и соли, впервые вошли перетертые помидоры. Примерно в это же время начали массово готовить и томатный суп гаспачо.
- 1893 г. Верховный суд США единогласно признал, что помидоры следует считать овощами, поскольку они подаются на обед, а не на десерт. Однако с ботанической точки зрения томаты - это многогнездные синкарпные ягоды.
Трудности перевода
Слово «томат» восходит к ацтекскому tumatle - «большая ягода». «Помидор» происходит от фр. pomme d'or - «золотое яблоко». Латинское название Solanum lycopersicum переводится как «волчий персик». Во Франции долгое время помидор называли помдамур - «яблоко любви». Была такая традиция: если девушка дарит парню плод красного томата - это знак пылкости ее чувств. Отсюда и пошла поговорка: «Прошла любовь - завяли помидоры».
MADE IN CHINA
Согласно данным FAO (Продовольственная и сельскохозяйственная организация ООН), ежегодно самый богатый урожай томатов -в Китае. Здесь собирают почти 53 млн. тонн.
Пятерка лидеров выглядит так (цифры - в млн. т):

Скажи депрессии «нет»
Энергетическая ценность 100-граммовой мякоти - 22 ккал.
В этом объеме:
- 94,8 г воды,
- 4,4 г углеводов,
- 0,6 г белков,
- 0,2 г жиров.
Состав насыщен витаминами и полезными микроэлементами (в процентном соотношении от средней суточной нормы здорового взрослого человека).
- 89% Витамин С. Борется с инфекциями и воспалением, укрепляет кровеносные сосуды.
- 20% Витамин А. Улучшает зрение, ускоряет регенерацию кожных покровов.
- 10% Калий. Нормализует сердечный ритм.
- 5% Витамин В6. Вырабатывает серотонин - «гормон счастья».
- 3% Фосфор. Поддерживает здоровье костной ткани и зубов.
- 3% Магний. Помощник при нервных расстройствах и стрессе.
- 1% Кальций. Укрепляет кости.
Сушеные томаты богаты ликопином - мощным антиоксидантом, снижающим вред ультрафиолетовых лучей.
Холодильник-убийца
Хранить помидоры в холоде нельзя, потому что температура до +10 разрушает входящие в его состав летучие вещества - соединения, воспринимаемые органами чувств как ароматы. Томат теряет вкус, становится водянистым. Поэтому идеальные условия для помидора - комнатная температура, сухое, нетемное место.
Лечит покалеченных
Мякотью спелых плодов лечат ожоги и раны. Быстрый эффект наблюдается из-за фитонцидов, препятствующих развитию инфекции. Актриса Настасья Самбурская на себе испытала чудодейственные свойства красного лекаря:
- Вас оса кусала? Лайфхак «пальчик в помидорку» работает на отлично: снимает боль и не даст пальцу распухнуть.

Интересные факты о кухне. Интересные факты о кухнях разных народов мира
Все мы любим хорошо и вкусно покушать. Мы готовим блюда дома – полезные и не очень, и радуем себя походами в кафе и рестораны, чтобы попробовать то, что дома приготовить не получается. Но что мы знаем о кухнях мира, за которыми идем в ресторан? Только то, что в Италии самое знаменитое блюдо – паста? Или то, что в Индии и Мексике еда такая острая, что даже русский экстремальный любитель будет чувствовать себя огнедышащим драконом. А ведь есть множество интересных фактов о кухнях разных народов мира. О них и расскажем.
Интересные факты о кухнях разных народов мира
Индия

Если вы бывали в индийских ресторанах, то наверняка видели в меню, а может даже и пробовали, большое разнообразие мясных блюд. Здесь на выбор и баранина, и свинина, и курица. Можно найти все, за исключением говядины (для тех, кто не в курсе: корова в Индии священное животное и употребление ее мяса в пищу для индуса – табу). Но не многие знают, что настоящая индийская кухня это, в основном, вегетарианские блюда: рис, дал (обобщенное название различных бобовых культур), лепешки, огромное количество специй и сыр (панир). Еще один интересный факт: в Индии растет около 50 сортов бананов! Бананы, которые мы привыкли видеть на прилавках магазинов, называются там «робаста морис», а еще есть «медовый банан» и «красный банан». А один из сортов «зеленых бананов» вообще считается овощем и в сыром виде не употребляется, из него готовят банановые чипсы или варят.
Мексика

Еда в Мексике острая – это знают все, но не каждый знает, что придает остроту пище не один и не два сорта перца. В Мексике насчитывается около 80 сортов перца чили! Кукуруза присутствует практически в каждом блюде мексиканской кухни и является чуть ли не национальным растением. А вот свой национальный напиток – текилу – мексиканцы, в отличии от представителей других стран, пьют без соли и лайма.
Япония

В Японии можно позволить себе почавкать без замечаний от соседей по столу, мало того – если вы не причмокиваете, когда едите жидкую пищу, то японцы посчитают, что блюдо вам не понравилось, и могут обидеться. А еще в Японии очень дорогие фрукты: одно яблоко или персик стоит около 2 долларов, что при нынешней экономической ситуации просто баснословно дорого.
Китай

Благодаря китайцам мы можем позволить себе такое лакомство как мороженое. Именно в Китае его впервые и приготовили, да еще из чего – первая порция была сделана из молока и снега! А еще в Китае за столом можно не аккуратничать, если вы посадили пятно на скатерть – это считается комплиментом повару. В Китае считают, что количество жирных пятен на скатерти прямопропорционально вкусу еды: чем больше пятен, тем вкуснее были блюда. А если вдруг в гостях в доме китайца при подаче чая чайник поставили так, что носик направлен на вас, то знайте – гость вы нежелательный, нужно уходить. По традиции подавая чайник нельзя направлять его носиком на гостей.
Интересные факты об апельсиновом соке. Полезные свойства
Чем меньше дополнительных компонентов ингредиентов входит в сок, тем он натуральнее и, соответственно, полезнее. Фреш с мякотью предпочтительнее других его видов, потому что он является «живым» и не содержит сахара. Такой напиток имеет средний гликемический индекс — 40, что позволяет включать апельсиновый сок в рацион питания при диабете.
Этот цитрусовый напиток оказывает множество полезных эффектов на человеческий организм:
- мочегонный;
- сокогонный;
- гипотензивный;
- кроветворный;
- сосудоукрепляющий;
- антиатеросклеротический;
- кровоостанавливающий;
- кровоочищающий;
- противоотечный;
- антиканцерогенный.
Свежевыжатый сок может принести пользу при склонности к запорам, а его низкая калорийность делает его диетическим продуктом. Эти свойства напитка позволяют включать его в рацион диетического питания желающих сбросить лишний вес.
Чтобы полезные свойства апельсинового сока проявились в полной мере, нужно знать, как его правильно пить. Здоровым людям фреш лучше пить утром на завтрак. При этом делать это необходимо не на голодный желудок, а после приема пищи.
При некоторых заболеваниях (при гастритах с пониженной кислотностью, дискинезиях желчевыводящих путей) необходимо пить апельсиновый сок натощак, но перед употреблением нужно разбавить его водой напополам. В остальных случаях при заболеваниях органов пищеварения, которые не являются противопоказаниями, напиток из этих цитрусовых лучше пить после еды, иначе его низкая кислотность при приеме его внутрь натощак будет раздражать слизистую желудка.
Ежедневное употребление апельсинового фреша по утрам повышает настроение и жизненный тонус, укрепляет иммунитет, улучшает пищеварение, предупреждает запоры.
Если человеку хочется апельсинового сока, то это значит, что в его организме есть дефицит каких-то веществ, которые содержатся в этих цитрусах, чаще всего, это недостаток витамина С.